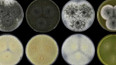
Houba pojmenovaná po českém vědci

11. června 2024
Část: Zákon o změnách v RTVS na Slovensku
Obsah dílu
Inflace za květen — Vliv cen na poptávku a spotřebu — Vývoj spotřebitelských cen — Ceny zboží a služeb — Hledání nového generálního tajemníka NATO — Konference o Ukrajině v Berlíně — Soud s bývalým důstojníkem Pohraniční střáže — Následky bleskových povodní — Bleskové povodně ve Valašských Kloboukách — Rada bezpečnosti o situaci v Gaze — Mezinárodní konference pro Gazu — Film Vzor líčí šikanu i vztek mladých — Změny ve sněmovně — Odstranění havarovaného vlaku v Pardubicích — Houba pojmenovaná po českém vědci — Policisté na Děčínsku — Blesková povodeň ve Valašských Kloboukách — Nasycení půdy vodou — Srážky v květnu — Průtok vody v řekách — Opatření proti suchu — Novela zákona o držení střelných zbraní — Zákon o změnách v RTVS na Slovensku — Porota uznala Huntera Bidena vinným — Přípravy opravy mostu v Ústí nad Labem — Hořící auto v Praze — Vlak poháněný energií z baterií — Připomínka vyhlazení francouzské vesnice nacisty — Zájem o školy v přírodě — Nemovitosti v Číně — Jednání o nové spalovně v Písku — Seriál o astronautce Sally Rideové
- Vyrobeno 2024
- Země původuČesko
Části dílu

Přehled dílů

15. května
Headlines — Změny rozpočtových pravidel — Koalice prosadila změnu rozpočtových pravidel — Změny scvhálené sněmovnou — Jednání Trumpa se Siem bez konkrétních dohod — Šéf CIA jednal s politiky na Kubě — Lebka sv. Zdislavy je zalitá v betonu — Výroba osobních aut — Srážky v Beskydech a sucho na Vysočině v jižních Čechách — Statistiky přijetí na střední školy — Pentagon zrušil rotaci tisíců vojáků v Polsku — Držitel Nobelovy ceny za literaturu na Světě knihy — Fico kritizoval média i opozici — Návrh akceleračních zón — Přerušený provoz na trati z Brna do Jihlavy — Irský běžec se po kolapsu vrátil na pražský maraton — Využívání kamer s rozeznáváním obličejů — Ukradená lebka sv. Zdislavy je zalitá v betonu — Práce restaurátorů na záchraně relikvie — Význam svaté Zdislavy pro věřící — Zabezpečení památek — Připomínky k návrhu zákona o veřejnoprávních médiích — Začalo hokejové mistrovství světa — Epidemie Eboly v Demokratické republice Kongo — Problémy libanonské ekonomiky — Tribunál pro ruské zločiny — Rekultivace krušnohorské krajiny — Svatojánské slavnosti Navalis — Svatojánské procesí — Výměna zajatců mezi Ruskem a Ukrajinou — Poklesl objem zboží přepravovaného letadly — Český zpěvák postoupil do finále Eurovize — Sochař Otmar Oliva uzavírá aktivní uměleckou kariéru

15. května
Znakový jazyk a skryté titulky
Znakový jazyk a skryté titulky

14. května
Headlines — USA a Čína se shodly na vzájemném partnerství — Jednání mezi delegacemi USA a Číny — Obchodní jednání mezi USA a Čínou — Ekonomická spolupráce USA a Číny — Přivítání Donalda Trumpa v Číně — Mimořádná schůze k sudetoněmeckému sjezdu — Dluhopisy Republiky pro občany — Kolona kamionů z Jihlavy až do Brna — Aktuální situace na dálnici D1 — Změny v superdávce — Další rozsáhlý ruský útok proti Ukrajině — Bývalý šéf ukrajinské prezidentské kanceláře Jermak ve vazbě — V Plzni zavřelo poslední casino — Druhé semifinále soutěže Eurovize — Rezignace britského ministra zdravotnictví — Debaty o umístění prvního modulárního reaktoru — Klamání zákazníků snížením gramáže výrobku — Opilý řidič ujížděl policii v Českých Budějovicích — Vyšetřování krádeže lebky sv. Zdislavy — Horské oblasti trápí sucho — Srážky v příštích dnech — Hodinová předpověď deště — Co stojí za výkyvy počasí — Proměnlivé počasí v průběhu týdne — Příští týden se oteplí — Kamerový systém v Krkonoších — Protesty v Havaně kvůli výpadkům elektřiny — Částečné uvolnění Hormuzského průlivu — Slavia získala titul před prázdnými tribunami — Požár bateriového úložiště v Nové Pace — Čtvrtletní výsledky ČEZ — Převoz hrocha z Jihlavy do Tel Avivu — Roste zájem o zbrojní průkazy — Pomoc obětem trestných činů — Svět knihy — Na Hradě začala rekonstrukce Královského letohrádku

14. května
Znakový jazyk a skryté titulky
Znakový jazyk a skryté titulky

13. května
Headlines — Růst cen v dubnu zrychlil — Výdaje českých domácností — Vývoj spotřebitelských cen — Většina íránských raket je podle CIA dál použitelná — Donald Trump na návštěvě Číny — Koalice chce uvolnit pravidla rozpočtové odpovědnosti — Pět let za neoprávněné restituce — Zastupitelé Jičína rozhodovali o změnách územního plánu — Češi loni vytřídili více odpadu — Třídění odpadu — Masivní ruský útok na západ Ukrajiny — Jedna jízdenka pro cestování vlakem napříč Evropou — Festival v Cannes ovládly francouzské a válečné filmy — Tradiční projev krále v britském parlamentu — Likvidace pyrotechniky v Jihlavě — Plánovaná opatření na stadionech — Pokračování fotbalové ligy po výtržnostech v Edenu — Slavia hostí Jablonec před prázdnými tribunami — Odcizená lebka sv. Zdislavy — Bazilika svatého Vavřince a svaté Zdislavy v Jablonném v Podještědí — Výzkum lebky svaté Zdislavy — Motivace ke krádeži církevní relikvie — Krádeže církevních památek — Bezdomovectví a bytová nouze dopadá na desítky tisíc dětí — Znečištění řeky Moravy neznámou látkou — Severní Korea řeší prudký nárůst automobilů — Nákaza norovirem na výletní lodi — Opakované případy kamenů na kolejích — Nový Úřad pro rodinu a ochranu dětí — Riziko ranních mrazů může trvat až do víkendu — Setkání lídrů Bukurešťské devítky — Osvěta rakoviny — Psychologická pomoc pro lidi s onkologickým onemocnením — 10. ročník festivalu ZUŠ Open

13. května
Znakový jazyk a skryté titulky
Znakový jazyk a skryté titulky

12. května
Headlines — Tresty za výtržnosti během fotbalového derby — Tresty pro fotbalové kluby — Opatření SK Slavia Praha — Použití systému na rozpoznávání obličejů — Fotbalový zápas mezi Spartou a Plzní — Trump zvažuje obnovení útoků na Írán — Trump míří na návštěvu Číny — Korupční kauza na Ukrajině — Ubylo nezaměstnaných — Prezident podepsal seznam nových velvyslanců — WHO čeká další případy hantaviru — Začíná hudební festival Pražské jaro — Hodnocení výdajů na obranu Severoatlantickou aliancí — Česko a Francie posilují spolupráci v jaderné energetice — Teploty v Česku klesly — Škody po silných bouřkách — Průměrná cena oběda přesáhla 200 Kč — Ceny za obědy v krajích — Levné obědy jako výjimka — Evakuace v Brně kvůli poškozenému jeřábu — Trest pro starostku obce Dobříkov — Omezení sociálních sítí pro děti — Násilí na dětech — Starmer čelí výzvám k odstoupení — Izrael schválil tribunál pro útoky ze 7. října — Čínský občan čelí obžalobě ze špionáže — Sovětská vlajka na písecká radnici — Razie v Ústřední vojenské nemocnici — Příbeh Jindřicha Berana prvvního padlého pilota na západní frontě — Podpora duševního zdraví zdravotníků — Evropě chybí datová centra pro rozvoj AI — Potvrzený trest pro bývalého řidiče tramvaje — Začíná mezinárodní filmový festival v Cannes

12. května
Znakový jazyk a skryté titulky
Znakový jazyk a skryté titulky

11. května
Headlines — Výdaje na obranu — Výdaje na obranu v roce 2026 — Nový zmocněnec pro plnění závazků vůči NATO — Nižší výdaje na obranu pociťují i zbrojovky — Další nakažení hantavirem — Stav ekonomiky během 1. čtvrtletí — Soud potrestal bývalou abatyši za zpronevěru — Koaliční rada o celostátním referendu — Týden od požáru v Českém Švýcarsku — Jednání mezi USA a Íránem — Končí příměří mezi Ruskem a Ukrajinou — Dar pro Lidickou sbírku umění — Začal proces v kauze Očistec — Maximální ceny paliv — Krádeže nafty na Vysočině — Restaurace soch ze staroměstského orloje — Nezákonné poplatky v ordinacích — Českem procházejí bouřky — Omezení spotřeby vody — Bezpečnost na stadionech — Pyrotechnika a chaos při derby — Zásah bezpečnostních složek na stadionu — Reakce na výtržnosti během zápasu — Potíže se stádem koz — Kritika premiéra Starmera z řad vlastních poslanců — Bavorský premiér navštíví sjezd sudetských Němců v Brně — Bedřichov chce zachránit sjezdovky v obci — Spor o sovětskou vlajku v Písku — Návrh na zavedení mistrovské zkoušky — Muž byl zaklíněný v lese tři dny — MHD v Klatovech bude zdarma — Sbírka na vyhořelou záchrannou stanici

11. května
Znakový jazyk a skryté titulky
Znakový jazyk a skryté titulky



